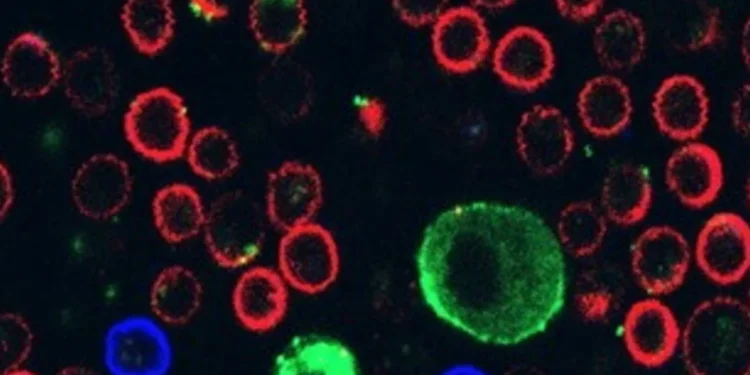

Por Alessandro Vittorio Romano — Em um estudo coordenado pela Tel Aviv University e publicado na revista Cell, pesquisadores identificaram um mecanismo silencioso e quase poético pelo qual o melanoma engendra a sua sobrevivência: o tumor libera minúsculas estruturas membranosas, as vesículas extracelulares, que agem como mensageiras tóxicas e interrompem a ação dos defensores naturais do corpo — os linfócitos T.
Guiada por Carmit Levy, a equipe examinou o comportamento das células de melanoma nas fases iniciais do desenvolvimento e durante o contato com o sistema imune. Os resultados mostram que as células tumorais secretam vesículas extracelulares carregadas de moléculas capazes de aderir, de forma seletiva, aos receptores dos linfócitos T CD8. Esse encontro prejudica a função citotóxica desses linfócitos e pode até induzir sua morte.
Essas vesículas, já conhecidas por facilitar a criação de um microambiente favorável à progressão tumoral, revelam aqui um papel adicional: a de ferramenta de evasão imunológica. Ao ligar-se aos receptores dos linfócitos, os ligantes na superfície das vesículas impedem que as células de defesa reconheçam e ataquem o tumor com eficácia — como se o melanoma soprasse um véu sobre sua própria presença.
O melanoma é a forma mais agressiva de câncer de pele e, em estágios avançados, possui elevada capacidade metastática. Compreender como o tumor escapa da vigilância imunológica é um passo essencial para aprimorar a eficácia das atuais estratégias de imunoterapia. A descoberta de Levy e colaboradores sugere caminhos terapêuticos promissores: bloquear a interação entre as vesículas extracelulares e os linfócitos, ou fortalecer a resistência dos linfócitos à ação tumoral.
Ainda assim, os autores são cautelosos. Serão necessários estudos experimentais adicionais e ensaios clínicos para avaliar como traduzir esses achados em tratamentos efetivos para pacientes. A pesquisa abre uma janela sobre a intimidade entre tumor e sistema imune — uma dança silenciosa na qual o câncer tenta tomar a lead.
Como alguém que observa a vida italiana entre estações e rotinas, imagino essa interação como a respiração da cidade: por vezes tranquila, por vezes turva. O tumor, como uma sombra que se espalha nas ruelas, usa suas pequenas vesículas para encobrir suas pegadas. Cabe à ciência — e às futuras terapias — redescobrir os caminhos que permitam ao corpo retomar seu ritmo, recuperar a colheita de hábitos saudáveis que sustentam o bem-estar.
Em suma, o estudo de Tel Aviv lança luz sobre um mecanismo de evasão imunológica do melanoma e aponta para novas estratégias terapêuticas em potencial, sem perder de vista a necessidade de validação clínica. É um convite para que a comunidade científica responda com criatividade e rigor, transformando essa nova compreensão em cuidados que devolvam proteção e esperança aos pacientes.